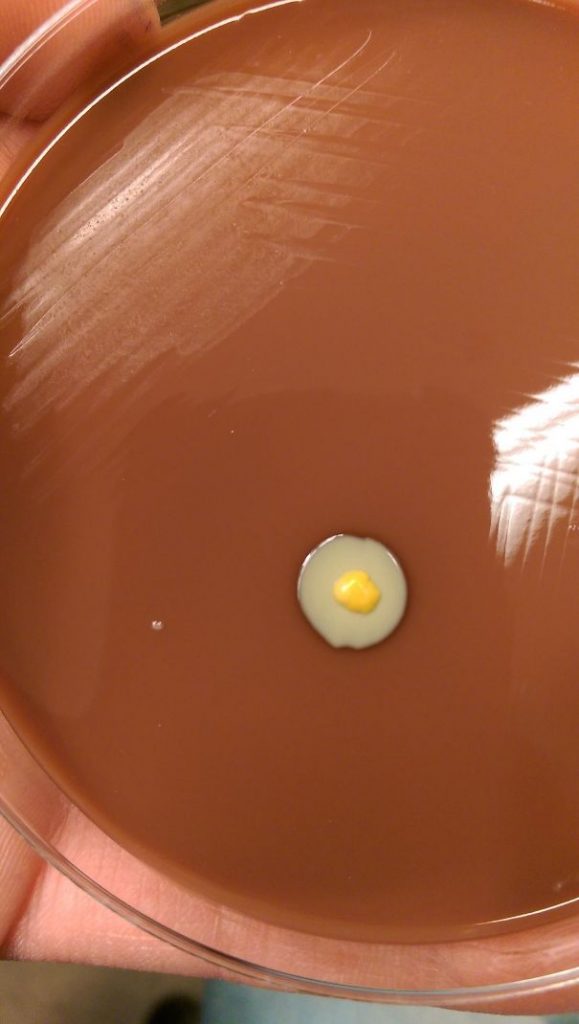

Έχετε φτάσει ποτέ στο σημείο να πεινάτε τόσο πολύ που όλα γύρω σας μοιάζουν με φαγητό και μάλιστα νόστιμο; Μάλλον, οι πολλοί από εμάς έχουμε φτάσει αρκετές φορές σε αυτό το σημείο.
Δείτε παρακάτω 40 φορές που πράγματα έμοιαζαν με φαγητό, αλλά δεν ήτα.
1.Αυτό το μπαλάκι του γκολφ που μοιάζει με κρέας
 guntycankles
guntycankles
2. Βράχος από μπέικον
 Rezrkt
Rezrkt
3. Δέντρο που μοιάζει με μπρόκολο
 Bdogg242
Bdogg242
4. Έδαφος που μοιάζει με τιραμισού
 zakaria14
zakaria14
5. Σκυλάκια ή φτερούγες κοτόπουλου;
 bfranks24
bfranks24
6. Μανιτάρι που μοιάζει με ντόνατ σοκολάτας
 PixiePooper
PixiePooper
7. Οδοντόκρεμα που μοιάζει με σολομό
 NECRO_PASTORAL
NECRO_PASTORAL
8. Λάστιχο που μοιάζει με φλούδα μπανάνας
 ButtStubble
ButtStubble
9. Δέντρα που μοιάζουν με ανανάδες
 notnexus
notnexus
10. Το σαπούνι μετά τον φούρνο μικροκυμάτων μοιάζει με ψωμί
 Horacioo
Horacioo
11. Πέτρα που μοιάζει με τοστ
 SirEleventy
SirEleventy
12. Στρώμα που μοιάζει με παγωτό
 njbolinger
njbolinger
13. Καραμέλα που μοιάζει με ωμό κρέας
 eeyore134
eeyore134
14. Μανιτάρι που μοιάζει με τεράστιο ντόνατ σοκολάτας
 corrikopat
corrikopat
15. Πολύτιμος λίθος που μοιάζει με σοκολάτα
 Robinwatcher80
Robinwatcher80
16. Πέτρα που μοιάζει με πατάτα
 dasmahhamma
dasmahhamma
17. Γάτα-κρουασανάκι
 TimeForTiffin
TimeForTiffin
18. Γυαλόχαρτο που μοιάζει με μπριζόλα
 StefanodesLocomotivo
StefanodesLocomotivo
19. Φύλλο που μοιάζει με μπανάνα
 SalmonNigiri
SalmonNigiri
20. Πέτρα που μοιάζει με μπέικον
 with_spork_i_thrust
with_spork_i_thrust
21. Πέτρωμα που μοιάζει με μπουρίτο
 with_spork_i_thrust
with_spork_i_thrust
22. Μωρό-ακτινίδιο
 Šarūnė Mac
Šarūnė Mac
23. Γλυκοπατάτα που μοιάζει με σολομό
 lozza_lorn
lozza_lorn
24. Εξάρτημα που μοιάζει με μπισκότο
 BeeneMachine
BeeneMachine
25. Μανιτάρι που μοιάζει με ζαχαρωτό και σοκολάτα
 fender0011
fender0011
26. Μέδουσα που μοιάζει με τηγανιτό αυγό
 Šarūnė Mac
Šarūnė Mac
27. Λουλούδι που μοιάζει με μπέικον
 paipo
paipo
28. Αυτή η πέτρα μοιάζει με κομμάτι κρέας
 Typical__Tim
Typical__Tim
29. Πόρτα γκαράζ που μοιάζει με μπάρα σοκολάτας
 TheHumanGuitarman
TheHumanGuitarman
30. Η αντανάκλαση των μικρών μπισκότων μοιάζε με ένα τεράστιο μπισκότο
 robije
robije
31. Ινδικό χοιρίδιο που μοιάζει με μελιτζάνα
 robije
robije
32. Μασημένος ανανάς που μοιάζει με γαρίδα
 IllyriaGodKing
IllyriaGodKing
33. Γατάκι-ακτινίδιο
 Šarūnė Mac
Šarūnė Mac
34. Αυτό το κοχύλι μοιάζει με μπέικον
 baked_potatoes4
baked_potatoes4
35. Αυτό το μανιτάρι μοιάζει με μακαρόνια
 leiterF
leiterF
36. Ο τρόπος που μεγαλώνει αυτό το βακτήριο μοιάζει με τηγανιτό αυγό
rmarkham
rmarkham
37. Αυτό το μανιτάρι μοιάζει με πίτσα για χορτοφάγους
 timtime321
timtime321
38. Αυτή η πέτρα μοιάζει με καρδιά
 stumpfenheimer
stumpfenheimer
39. Μανιτάρι που μοιάζει με ποπ κορν
 krazybones
krazybones
40. Πέτρες που μοιάζουν με αυγά


 Slamchops
Slamchops
